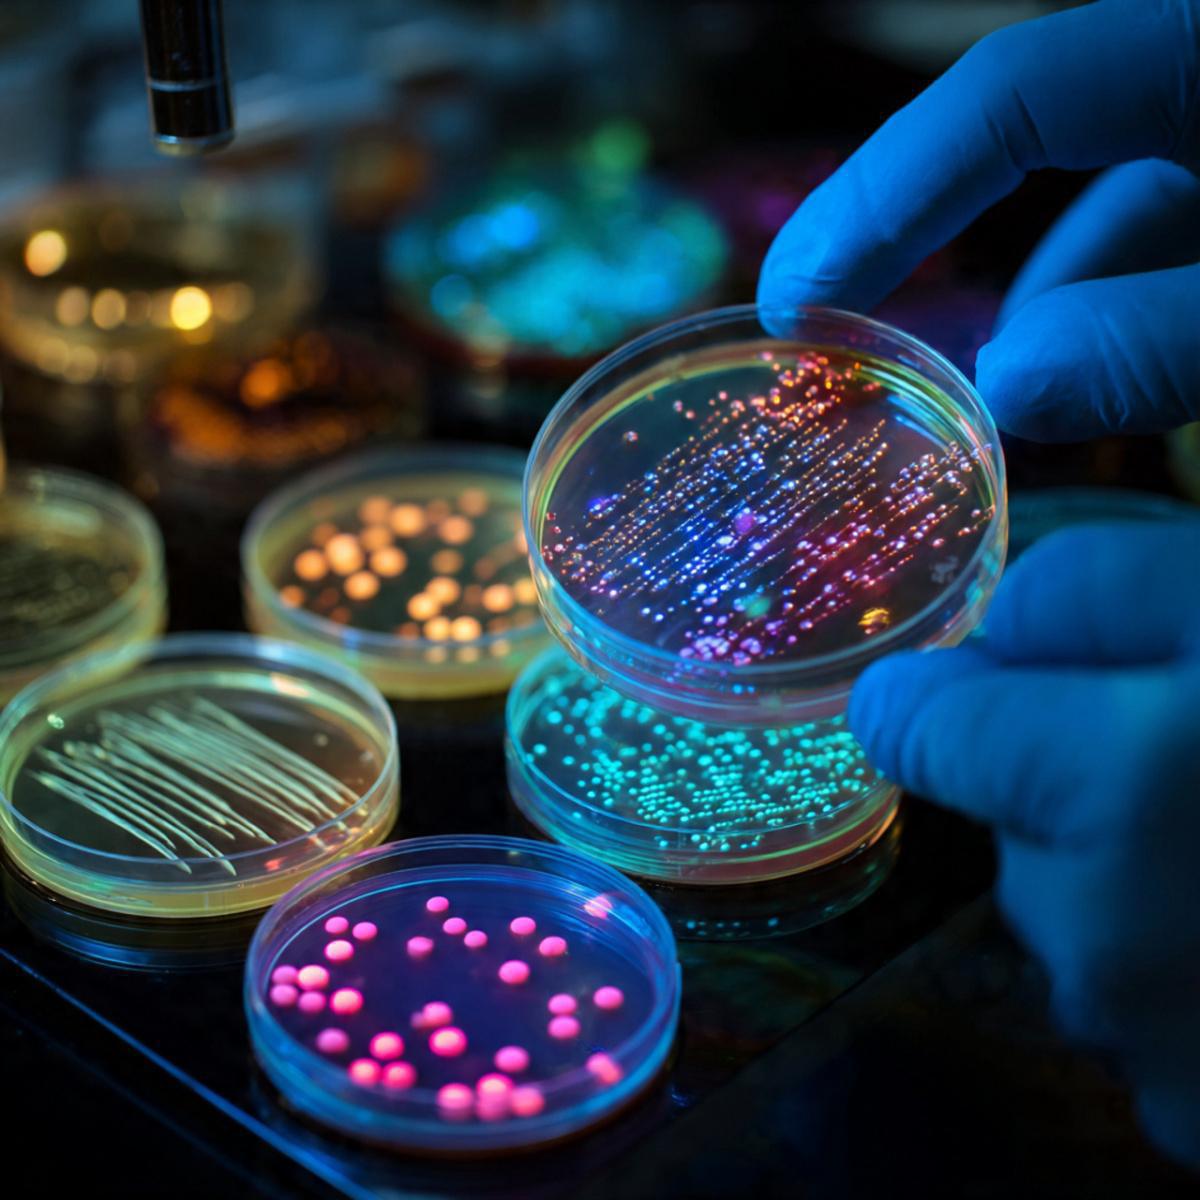
Are We More Bacteria Than Human? Are We More Bacteria Than Human?

It's a question that, by its very asking, seems almost sacrilegious to our self-image: are we more bacteria than human? Through the ages, we have assumed the body is a single, sovereign organism—an integrated whole under our control. Yet modern microbiology tells a different story. Our bodies are not individual entities but ecosystems, teeming with trillions of microbial inhabitants outnumbering our own cells. In many ways, you're less an "I" than a "we."
When researchers first compared the number of human and microbial cells, they were astounded. Early estimates said bacterial cells outnumber human cells 10 to 1. That number has since been revised—most today say it's closer to 1.3 to 1—but the message remains profound: we are, numerically speaking, microbial hybrids. While our human cells constitute the bulk of our mass, our microbial partners dominate by sheer count and genetic diversity. Collectively, their genes outnumber ours hundreds of times over, forming what scientists call the microbiome—a vast, symbiotic network that shapes who we are from the inside out.
Most of these microbes live in the gut, a world unto itself. Your gut harbors bacteria that ferment fiber, synthesize vitamins, train the immune system, and even affect mood. They communicate with the brain via the vagus nerve and manufacture neurotransmitters such as serotonin and dopamine. It is hardly an overstatement to say that your gut bacteria help determine how you feel, what you think, and even how you act. The gut-brain axis has remade the way science thinks about identity—not as a stable, human-centered essence but as a cooperative balance among many species.
But it doesn't stop there: your skin, lungs, mouth, and reproductive system are all habitats, too. And these microbes can act as the bouncers, bodyguards, and housekeepers of their realms, in competition with any pathogen, metabolizing oils and maintaining pH in a delicate balance. Every surface of your body is a carefully negotiated frontier. When you change your diet, use antibiotics, or switch soaps, you don't just change yourself—you reorganize a complex biological community. You're never alone, and you're never quite the same twice.
It acts against the traditional view of individuality in a bold way: if our health is dependent on a symbiosis with countless, unseen microscopic strangers, then where precisely do "we" end? As the philosopher Donna Haraway says, this is the symbiotic view of life, wherein organisms are always "becoming-with" rather than being alone. The body becomes dynamic collectives—temporary gatherings of human and non-human cells bonded by mutual survival. It blurs the line between self and other, biology and environment, autonomy and dependency.
The bacterial majority redefines how we think of evolution: Rather than as a linear process of genetic inheritance, our traits and vulnerabilities emerge from symbiotic relationships. Some bacteria provide metabolic capabilities humans never evolved. Others shape immune tolerance, allowing us to coexist with the microbial world, rather than wage constant war on it. And evolution itself, if viewed through this prism, looks less like a form of competition and more like a form of conversation—a slow negotiation across species lines.
Even our sense of self may be microbial. It's an unsettling yet strangely liberating reality that studies show changes in gut bacteria can alter mood, anxiety levels, and even decision-making in animals and humans alike. Maybe our consciousness, fully believed to be solely a human affair, could partly be co-authored by microscopic collaborators. When you crave chocolate, feel social, or fall into melancholy, it might not be entirely "you"-—it might be your bacteria speaking through you.
So, are we more bacteria than human? In terms of mass, no. But in terms of number, influence, and identity, perhaps yes. The human body is not a fortress but a federation-—an uneasy peace among species that learned to live together. It would appear that to be human is to be host, habitat, and home-—to carry multitudes within our skin and to recognize that life's boundaries are far blurrier than we once imagined.